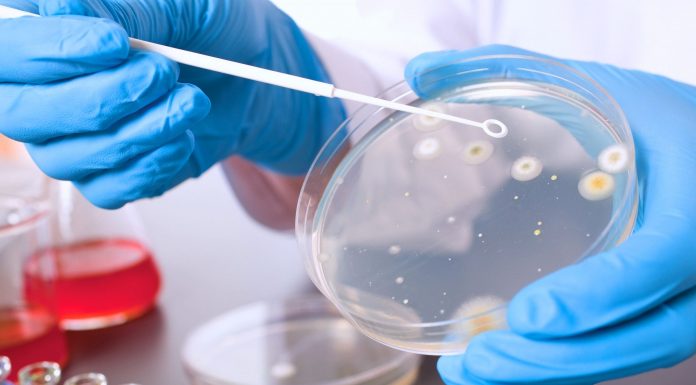
Com este remédio natural, você pode acabar com a bactéria Helicobacter Pylori.

Como todos nós sabemos, as moscas são bastante irritantes e importunas. Na realidade, a presença delas é prejudicial apenas para todos nós. No entanto, se moscas ou mosquitos invadiram sua casa, siga estas dicas para mantê-los afastados...
A doença de Alzheimer é bastante temerosa, conforme
avança essa condição, uma pessoa e seus entes queridos sofrem de uma forma
esmagadora.
A doença foi descoberta em 1906 pelo Dr. Alois Alzheimer e
desde lá poucos avanços foram...
Couve pode deixar cérebro 11 anos mais jovem e isto significa mais agilidade de raciocínio, mais motivação, mais capacidade de memorização e de aprendizado.
Você sabia que a couve foi usada por egípcios e...
Helicobacter Pylori é uma bactéria que se aloja no sistema digestivo de pessoas que em algum momento sofreram de um problema nesta parte do corpo. Na maioria das vezes, está presente em pessoas que sofreram câncer de...
Investindo muito esforço e esperança
Um grupo de brasileiros formado por professores e estudantes da Universidade Federal Fluminense, em parceria com a Fundação Oswaldo Cruz, buscam descobrir um medicamento contra a leucemia, doença...
Geralmente, nos momentos em que sentimos dores nos pés,
é mais indicado realizar uma massagem com óleo morno em todo pé,
persistindo nas áreas mais dolorosas
que, na maioria das vezes pode ser no
calcanhar e o peito do pé, mas...
Fibromialgia: sintomas e sua relação
com a depressão
Fibromialgia é considerada uma
síndrome de dor crônica de alta complexidade. Os sintomas comuns são dores
musculares e nas articulações, ambas generalizadas. Essa síndrome acomete o
sistema fibroso e muscular...
A pipoca de microondas que todos nós amamos provavelmente foi tratada com uma longa lista de produtos químicos tóxicos que incluem inseticidas, herbicidas, fungicidas e fumigantes.
Pipoca de microondas contém é carregado com todos...
Teste indolor e eficiente
Nos últimos anos vem sendo muito investigado a possibilidade de detectar o câncer, através do sangue, antes que ele seja evidente em uma mamografia. Os pesquisadores da Universidade alemã,...
A salsa é uma erva excepcional que combina benefícios à saúde e sabor clássico - um tempero popular e curador comprovado!
A salsa pode e deve ser usada extremamente intensamente agora que cresce e...